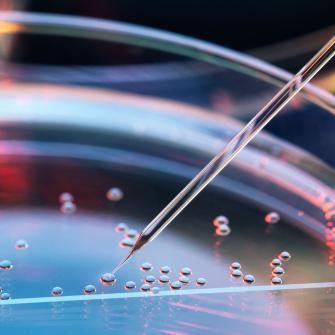

Division of Precision Medicine

The Division of Precision Medicine in the Department of Medicine at NYU Langone brings together clinicians and computational scientists to perform innovative, clinically relevant research in areas that include cardiovascular disease, diabetes, chronic kidney disease, and cancer. We are dedicated to bringing the fruits of research investigations to patients and the community.
Our faculty use information from electronic health records, clinical trials data, research cohorts, and biorepositories to enhance patient-specific healthcare and discover new therapies. We leverage medical records for disease risk prediction and pharmacoepidemiology, genetics and advanced single-cell and spatial multiomics technologies, artificial intelligence (AI)–assisted diagnosis from medical images, and mobile digital health applications with the goal of improving health.
Our Leadership
Our leadership provides faculty with guidance on research activities and resources within NYU Langone’s Division of Precision Medicine.

Morgan E. Grams, MD
Co-Director, Division of Precision Medicine
Professor, Departments of Medicine and Population Health

Aristotelis Tsirigos, PhD
Co-Director, Division of Precision Medicine
Professor, Department of Pathology
Our Research
Resources

Faculty & Staff

